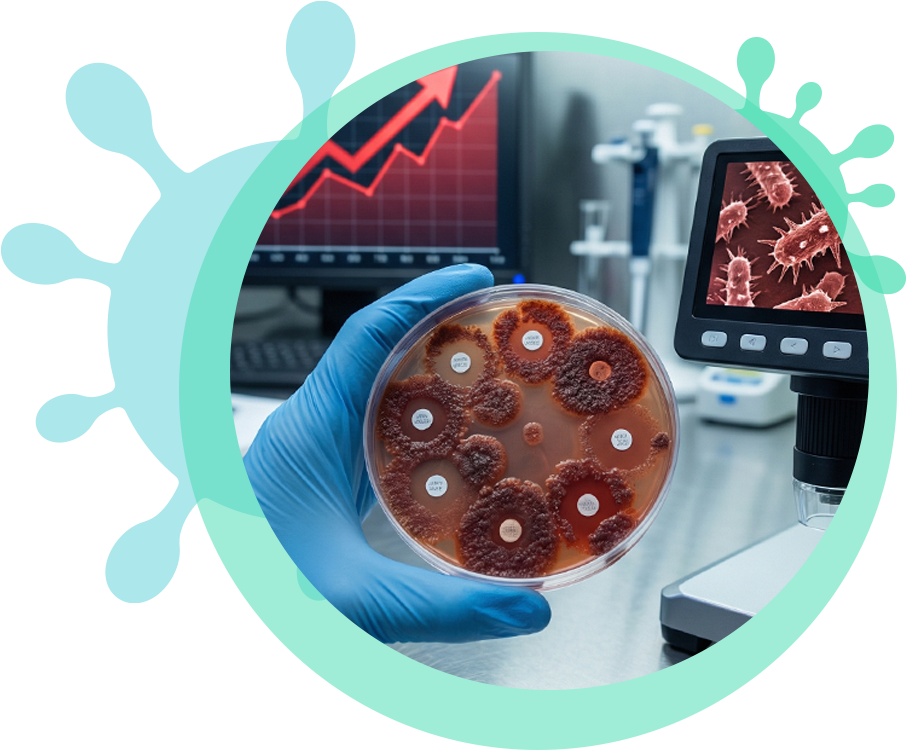

Az antimikrobiális rezisztencia (AMR): Egy globális kihívás
Az antimikrobiális rezisztencia (AMR) azt jelenti, hogy a kórokozók már nem reagálnak a korábban hatékony gyógyszerekre, ami az emberiség egyik legsúlyosabb globális egészségügyi kihívásává vált. A predikciók szerint 2050-re az AMR lesz a vezető halálok az emberekben, megelőzve a daganatos megbetegedéseket és a szív-érrendszeri problémákat. A rezisztencia kialakulásának fő oka az antibiotikumok túl gyakori vagy nem megfelelő használata (például vírusos megfázásra), ami egy természetes szelekciós folyamatot indít el. A rezisztenciát kódoló gének szinte mindenhol megtalálhatók, ahol élet van: a jégkorszakból származó mintáktól kezdve a levegőben, felhőkben, növényekben és állatokban.


A Nemzeti Laboratórium országos szintű felméréseket végez több mint 40 baromfi- és sertéstelepen, hogy megismerje az AMR hazai elterjedtségét. A kutatás aggasztó megfigyeléseket tárt fel: a kritikusan fontos fluorokinolon antibiotikumokkal szembeni rezisztencia házityúk esetén 50% körüli, pulykaállományokban pedig 60% körüli. Különösen riasztó, hogy a sertéseknél az ESBL-termelő (kiterjedt spektrumú antibiotikum-lebontó enzimet termelő) Escherichia coli törzsek aránya már közel 50%. A laboratórium a baktériumok közötti kommunikáció megértésére is fókuszál, mivel ezek az organizmusok „baktérium-közösségként” viselkednek és közösen „döntenek” a védekezési mechanizmusok bekapcsolásáról.
Az AMR igazi „One Health” problémának tekintendő, mivel ami az állatállományokban megjelenik, az előbb vagy utóbb az emberekhez is eljuthat élelmiszeren vagy környezeti úton keresztül. A laboratóriumi munka során gyűjtött trendek és előrejelzések célja, hogy megalapozzák azokat a szabályozásokat, amelyek még időben gátat vethetnek a helyzet további súlyosbodásának az EU és a WHO által sürgetett lépésekkel összhangban.